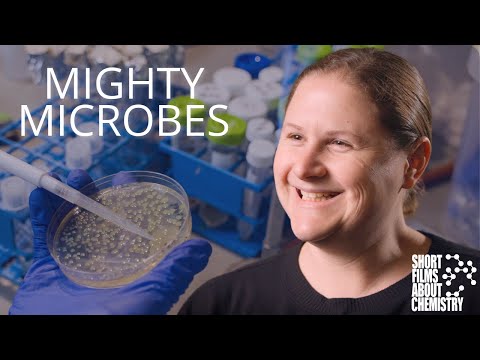
YouTube video

Sabitlenmiş Tweet
Our premiere of San Diego: America’s Wildest City— airs tonight on PBS at 8/7c. Tune out of politics, tune into nature: pbs.org/wnet/nature/ab… | #NaturePBS #SanDiego #hummingbird #whale #seal #grunion #squirrel #superbloom
English